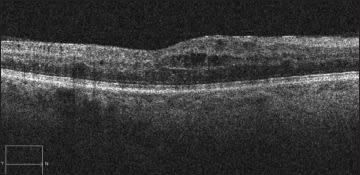
images

CASE STUDY
Reduction in CME From CRVO with Biweekly Avastin-Dexamethasone
MATTHEW J. WELCH, MD · CLIVE H. SELL, MD
A 61-year-old Caucasian woman presented at our practice with a prior diagnosis of a nonischemic central retinal vein occlusion of the right eye with four months of decreased visual acuity. Her medical history was significant for hypertension, and she was on oral hypotensive medication treatment.
Before presenting at our practice, she had been under the care of a retina specialist outside of our state, where she spends her summers. Previous treatment had included monthly bevacizumab (Avastin, Genentech, South San Francisco, Calif.) injections in the right eye.
At the time of our evaluation she had received a total of three injections without significant vision improvement or a reduction in central macular thickness on optical coherence tomography measurement.
At the time of our initial evaluation, visual acuity without correction measured 20/300 OD and 20/30 OS. Intraocular pressure, ocular motility, and confrontational visual field testing were all unremarkable OU. Amsler grid testing noted central distortion and blurring of the right eye, while the left eye was unremarkable.
The slit-lamp examination showed no iris neovascularization in the right eye and mild nuclear sclerotic lens changes OU. The dilated fundoscopic examination revealed intraretinal hemorrhages in all four retinal quadrants, with marked central macular edema in the right eye. The left eye showed a sharp foveal light reflex without peripheral pathology.
Fluorescein angiography demonstrated four-quadrant intraretinal hemorrhaging with central macular edema but no evidence of neovascularization. OCT showed massive intraretinal macular edema with a central macular thickness of 895 μm.
|
Matthew Welch, MD, is the senior vitreoretinal fellow at Associated Retina Consultants, Ltd., in Phoenix. Clive Sell, MD, is a practicing partner at Associated Retina Consultants, Ltd. Neither of the authors has any financial interests in the treatments discussed in this article. Dr. Welch can be reached via e-mail at mwelch11@gmail.com. |

Figure 1. Initial evaluation OCT macular cross-section OD, CMT 895 μm.
Figure 2. OCT macular cross-section following fourth combination injection, now at two-week intervals. CMT 293 μm.
A change to a combination of intravitreal injection of bevacizumab 1.25 mg with 800 µg dexamethasone in a 0.05-mL volume was our initial therapeutic intervention. Her treatment course is outlined in Table 1. Representative OCT images are shown in Figures 1, 2, and 3.
Following completion of 10 combination intravitreal injections in the right eye, she returned to her home state for the summer months and continued care.
DISCUSSION
For years, the treatment of macular edema secondary to CRVO has been complicated and limited. The Central Retinal Vein Occlusion Study (CVOS) group showed the benefits of panretinal photocoagulation therapy in the treatment of neovascularization. However, macular grid treatment in the setting of secondary macular edema offered no significant benefits.1’2
TABLE 1. TREATMENT INTERVAL, VISUAL ACUITY OD, AND CMT IN MICRONS DURING THE COURSE OF TREATMENT
| Treatment interval | Visual acuity (OD) | CMT (μm) |
|---|---|---|
| Initial evaluation (zero) | 20/300 | 895 |
| 6 weeks | 20/400 | 1296 |
| 3 weeks | 20/200 | 582 |
| 2 weeks | 20/80 | 350 |
| 2 weeks | 20/70 | 293 |
| 3 weeks* | 20/80 | 550** |
| 2 weeks | 20/40 | 323 |
| 2 weeks | 20/50 | 285 |
| 2 weeks | 20/60 | 302** |
| 2 weeks | 20/60 | 301** |
* THIS INTERVAL EXTENSION WAS UNPLANNED, AND THE PATIENT REPORTED HER BLOOD PRESSURE TO BE VERY ERRATIC IN THE PRECEDING WEEKS, REQUIRING CHANGES TO HER ORAL HYPOTENSIVE MEDICATION REGIMEN.
**SPECTRALIS HD-OCT IMAGING USED AT VISIT.

Figure 3. OCT macular cross-section following 10 combination injections. CMT 301 μm (Spectralis HD-OCT).
Therefore, for years, macular edema secondary to CRVO was without strong evidence in support of treatment. Thanks to the work of the SCORE and CRUISE study groups, it became clear that there are certainly treatment modalities with notable efficacy, which are able to reduce central macular edema and improve visual acuity in eyes suffering from macular edema secondary to CRVO.3,4
An additional consideration in treatment that has recently been discussed has focused on the exact treatment interval used with intravitreal bevacizumab therapy. In 2006, Bakri et al. presented to the American Society of Retina Specialists their study, which was later published in 2007, evaluating the pharmacokinetics of intravitreal bevacizumab in the eyes of rabbits.5
In this seminal study, they found intravitreal 1.25 mg bevacizumab to have a vitreous half-life of 4.32 days and showed a peak aqueous humor concentration at one week (29.4 ng/mL). The pharmacokinetic properties of bevacizumab revealed in this study have served as the foundation for consideration of more frequent intravitreal dosing of bevacizumab than the four- to six-week interval, which is often chosen for initial therapy.
One of the great difficulties now presented to vitreoretinal physicians treating macular edema secondary to CRVO is the selection of the therapeutic modality (steroids, anti-VEGF, and combination therapy), as well as the dosing frequency needed to reduce structural edema maximally and to optimize visual acuity. It remains unclear how best to identify those patients who will have the greatest magnitude of response to any one particular therapeutic option or combination therapy.
The frequency interval with which to dose intravitreal therapy also remains unknown, when attempting to formulate a therapeutic treatment plan specific to an individual patient. However, this case may serve as an example of how early consideration of combination therapy, along with reduced-dosing interval, can result in significant central macular edema reduction, coupled with visual acuity improvement, despite several months of therapy without significant clinical progress.
This case also illustrates the importance of blood pressure control and consistent treatment for cases of chronic severe macular edema secondary to CRVO. Our patient experienced significant regression and rebound macular edema following a period of poor blood pressure control. Such an occurrence further underscores the importance of counseling our patients regarding blood pressure control at each visit, even during ongoing intravitreal therapy.
We realize the limitations of a single case report, especially in a condition with a known broad variation in natural history, as well as in response to a variety of treatment modalities. However, in light of the dramatic improvement in both macular edema and visual acuity months after the initiation of monthly anti-VEGF therapy, we believe that further investigation, with additional clinical trials focused on combination therapy and dosing intervals, is warranted. RP
REFERENCES
1. The Central Vein Occlusion Study Group: A randomized clinical trial of early panretinal photocoagulation for ischemic central vein occlusion. The CVOS Group N Report. Ophthalmology. 1995;102:1434-1444.
2. The Central Vein Occlusion Study Group: Evaluation of grid pattern photocoagulation for macular edema in central vein occlusion. The CVOS Group M Report. Ophthalmology. 1995;102:1425-1433.
3. The SCORE Study Research Group. A randomized trail comparing the efficacy and safety of intravitreal triamcinolone with observation to treat vision loss associated with macular edema secondary to central retinal vein occlusion. Arch Ophthalmol. 2009;127:1101-1114.
4. Brown DM, Campochiaro PA, Singh RP, et al; for CRUISE Investigators. Ranibizumab for macular edema following central retinal vein occlusion: six-month primary end point results of a phase III study. Ophthalmology. 2010; 117:1124-1133.
5. Bakri SJ, Snyder MR, Reid JM, Pulido JS, Singh RJ. Pharmacokinetics of intravitreal bevacizumab (Avastin). Ophthalmology 2007;114:855-859.








